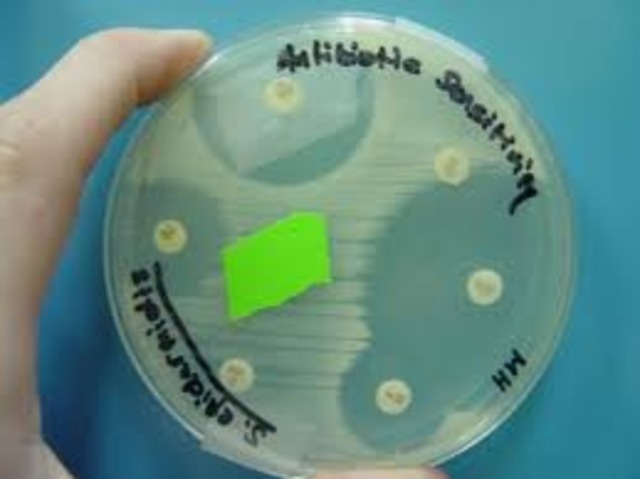
born

-
Born in Norwich, NY. Most adorable baby ever seen!
-
-
-
Sherburne Earlville High School
-
Married high school sweetheart!
-
State University of New York, College at Oneonta
-
Mitchell Owen Eveland
-
Found my working home
-
My universe expanded exponentially!
Want to make a timeline like this?
Use Timetoast to turn dates, events, milestones, and phases into a clear visual timeline you can build and share. Timetoast is a timeline maker for work, school, research, and stories.